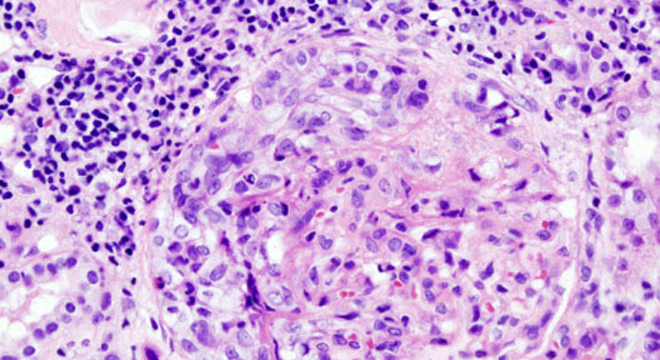

Die Glomerulonephritis ist eine entzündliche Erkrankung der Nieren.
Im engeren Sinn steht der Begriff Glomerulonephritis für eine entzündliche Veränderung der Nierenkörperchen (Glomeruli), welche zum Hauptteil aus einem Gefässknäuel bestehen, die den Primärharn filtrieren.
Im Gegensatz dazu gibt es nicht entzündliche Erkrankungen der Nierenkörperchen wie die typische Nierenerkrankung des Diabetikers. Bei einer Entzündung kann es sich grundsätzlich um eine infektiöse oder nicht infektiöse Erkrankung handeln.
Die Glomerulonephritis ist eine der häufigsten Ursachen für eine chronische Niereninsuffizienz, die eine Blutwäsche (Dialyse) notwendig machen.
Bestimmte Formen der Nierenentzündung verlaufen ohne grosse Einschränkung der Nierenfunktion, bei andern kann die Nierenfunktion total ausfallen. Ein totaler Ausfall der Nierenfunktion ist lebensbedrohlich.